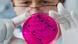
Foto: Patrick Pleul/lnw +++(c) dpa - Bildfunk+++ Foto: Patrick Pleul/lnw +++(c) dpa - Bildfunk+++

Scientists trace bacteria strain
November 30, 2012
Salmonella typhimurium, a leading cause of human gastroenteritis, is a strain of bacteria wreaking havoc among HIV-positive people in sub-Saharan Africa. According to the Wellcome Trust Sanger Institute, about 45 percent of those with weakened immune systems resulting from HIV die when infected with the salmonella strain.
Geneticists at the UK institute recently mapped the evolution of the bacterium, also known as invasive non-typhoidal salmonella or iNTS.
Mapping bacteria
Chinyere Okoro, one of the researchers responsible for charting the salmonella subspecies, said the team was able to trace the strain back to two areas in southern Africa, and also analyze the bacteria’s genetic makeup.
The analysis showed that the first epidemic originated about 50 years ago in southeast Africa. A more recent outbreak, Okoro said, followed 35 years ago and likely came from the Congo Basin.
"We were able to see parallels with the transmission and high incidences reported in HIV," Okoro added. "Invasive disease is due to salmonella typhimurium and is the hallmark of advanced AIDS."
Death rates from the bacterium are high in sub-Saharan Africa. Okoro said this number could be much less if people were able to get a proper diagnosis and treatment with adequate medications.
Access to medication
Nearly half of all AIDS patients who contract the salmonella strain in sub-Saharan Africa will die. Okoro said this reflects the shortcomings of the continent’s healthcare system. Of those who become infected with the same bacterium in industrialized countries, only 1 percent die.
"The picture is a little bit heterogeneous," said Joseph Perriens from the World Health Organization’s HIV Department. "There are countries in which people with HIV have quite decent access to services, in particular treatment for HIV infection, and others where that access is still developing."
Region-wide health development would address the problem, Perriens said, adding that it is important for patients with HIV to have access not only to specific treatments but also to a functioning healthcare system able to deal with diseases such as salmonella infections
As a result of its relatively effective AIDS response program, Malawi has shown a much lower incidence of typhimurium infection, said Okoro.
Moving forward
The next step for Okoro and her team is to determine how the bacterium is transmitted. Though other Typhoid-like bacteria typically reside in a host animal and are transmitted through the food chain, the findings for salmonella typhimurium transmission were different, according to Okoro.
"The disease can be passed from human to human," she said. "Now we have to go on to discover how iNTS is actually transmitted in sub-Saharan Africa. That would help in the intervention strategies that would have to be implemented."